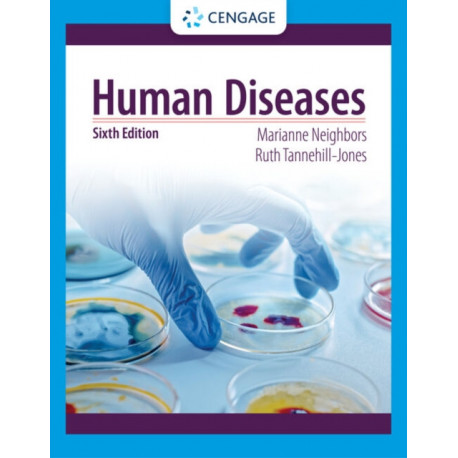
Human Diseases

Kurv
Vare
varer
(tom)
Ingen varer
Fastlægges senere
Forsendelse
0,- kr
I alt
Human Diseases
(Bog, Paperback / softback, Engelsk)
Forlag:
Cengage Learning, Inc
- Type: Bog
- Format: Paperback / softback
-
Sprog:
Engelsk

- ISBN-13: 9780357618042
- Se flere detaljer ▼
Formater og udgaver
Læsernes anmeldelser (0)
Alle detaljer
| Forlag | Cengage Learning, Inc |
| Forfattere | Marianne (University of Arkansas) Neighbors, Ruth (Mercy Health System Tannehill-Jones |
| Type | Bog |
| Format | Paperback / softback |
| Sprog | Engelsk |
| Udgave | 6 ed |
| Udgivelsesdato | 24-10-2022 |
| Første udgivelsesår | 2022 |
| Originalsprog | United States |
| Sideantal | 624 |
| Indbinding | Paperback / softback |
| Forlag | Cengage Learning, Inc |
| Sideoplysninger | 624 pages |
| Mål | 216 x 278 x 36 |
| ISBN-13 / EAN-13 | 9780357618042 |

